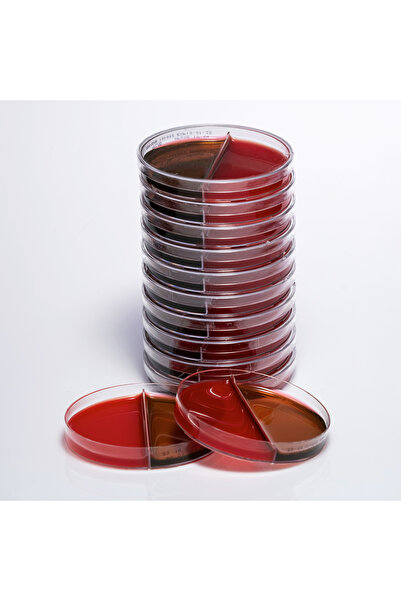
medexia Hazır Koyun Kanlı + EMB Besiyeri - 1 Paket (10 Adet)

Kadın
Erkek
Anne & Çocuk
Ev & Yaşam
Süpermarket
Kozmetik
Ayakkabı & Çanta
Elektronik
Saat & Aksesuar
Spor & Outdoor
Flaş Ürünler
Yeni
Çok Satanlar
Yeni
KadınGiyimElbiseTişörtGömlekKot PantolonKot CeketPantolonMontBluzCeketEtekKazakTesettürBüyük BedenTrençkotYağmurluk & RüzgarlıkSweatshirtKabanHırkaPaltoAyakkabıTopuklu AyakkabıSneakerGünlük AyakkabıBabetSandaletBotÇizmeKar BotuLoaferAksesuar & ÇantaÇantaSaatTakı CüzdanAtkıBereEldivenKemerŞalÇantaOmuz ÇantasıSırt ÇantasıBel ÇantasıOkul ÇantasıLaptop ÇantasıPortföyPostacı ÇantasıEl ÇantasıKanvas ÇantaMakyaj ÇantasıAbiye ÇantaÇapraz ÇantaBez ÇantaAnne Bebek ÇantasıEvrak ÇantasıTote ÇantaBeslenme ÇantasıKartlıkCüzdanKadın Spor ÇantasıEv & İç GiyimPijama TakımıGecelikSütyenİç Çamaşırı TakımlarıFantezi GiyimÇorapKorseKülotBüstiyerBraletAtlet & BodyKombinezonJartiyerKozmetikParfümGöz MakyajıCilt BakımSaç BakımıMakyajAğız BakımCinsel SağlıkVücut BakımHijyenik PedDuş Jeli & KremleriRujDudak NemlendiriciAydınlatıcı & HighlighterEyelinerTen MakyajıManikür & PedikürBB & CC KremEl KremiYüz NemlendiriciSpor & OutdoorSweatshirtTişörtSpor SütyeniTaytEşofmanKoşu Ayakkabısı Spor ÇantasıSpor EkipmanlarıOutdoor AyakkabıKar BotuOutdoor EkipmanlarıSporcu BesinleriSporcu AksesuarlarıOutdoor ÇantaKayak MalzemeleriUyku TulumuMatDağcılıkKadın Spor CeketSpor AyakkabıErkekGiyimTişörtŞortGömlekEşofmanPantolonCeketKot PantolonYelekKazakMontTakım ElbiseSweatshirtDeri MontKabanHırkaTrençkotPaltoYağmurlukBlazerPolarAyakkabıSpor AyakkabıGünlük AyakkabıYürüyüş AyakkabısıKramponSneakerKlasikBotKar BotuDeri ayakkabıLoaferEv TerliğiKoşu AyakkabısıÇizmeKişisel BakımParfümCinsel SağlıkTıraş BıçağıDeodorantÇantaSırt ÇantasıSpor ÇantaLaptop ÇantasıValiz & BavulPostacı ÇantasıBel ÇantasıBez ÇantaEvrak ÇantasıCüzdanBüyük BedenBüyük Beden SweatshirtBüyük Beden T-shirtBüyük Beden GömlekBüyük Beden PantolonBüyük Beden MontBüyük Beden KazakBüyük Beden HırkaBüyük Beden KabanBüyük Beden Eşofman AltıSaat & AksesuarSaatGüneş GözlüğüCüzdanKemerÇantaŞapkaKartlıkValizKravatBoyunlukAtkıBereEldivenİç GiyimBoxerÇorapPijamaAtletİçlikSpor & OutdoorEşofmanSpor AyakkabıT-shirtSweatshirtFormaSpor ÇorapSpor GiyimOutdoor AyakkabıOutdoor BotSpor EkipmanlarıOutdoor EkipmanlarıSporcu BesinleriSporcu AksesuarlarıSneakerScooterBisikletDalış MalzemeleriRüzgarlıkAksiyon KamerasıKamp MalzemeleriElektronikTıraş MakinesiCep TelefonuAkıllı SaatAkıllı BileklikLaptopOyun & KonsollarElektrikli BisikletE-pin ve Cüzdan KoduPlaystation 5Hediye KartlarıBluetooth KulaklıkGaming PCOyuncu KoltuğuDroneAnne & ÇocukBebekBebek TakımlarıAyakkabıHastane ÇıkışıYenidoğan KıyafetleriTulumBody & ZıbınTişört & AtletElbiseŞortBebek PatiğiHırkaBattaniyeAlt Üst TakımTişörtEtekÇorapŞapkaEldivenEşofmanBereKız ÇocukElbiseSweatshirtSpor AyakkabıEşofmanİç Giyim & PijamaTişört & AtletTaytGünlük AyakkabıŞortMontÇocuk Oyun EviOyuncak BebekKabanAbiye & ElbiseCeketPantolonKazakBotŞapka & Bere & EldivenErkek ÇocukSweatshirtSpor AyakkabıEşofmanİç Giyim & PijamaTişört & AtletGünlük AyakkabıOkul ÇantasıŞortGömlekMontOyuncak TraktörAkülü ArabaKumandalı ArabaBisikletBoxerİçlikBotKramponŞapka & Bere & EldivenTakım ElbiseBebek BakımBebek BeziBebek ŞampuanıKrem & YağlarBebek ÇantasıBebek SabunlarıBebek DeterjanlarıBebek Vücut KremiIslak MendilBebek YağıBebek Buhar MakinesiOyuncakEğitici OyuncaklarOyuncak ArabaOyuncak BebekBebek & Okul ÖncesiKumandalı OyuncakRobot OyuncakÇocuk Çizim TabletiBeslenme EmzirmeBiberon & EmzikGöğüs PompasıMama SandalyesiMama ÖnlüğüAlıştırma BardağıBiberon TemizleyiciBiberon SetiBebek MamasıKavanoz MamaSterilizatörBebek Bakım ÇantasıYemek SetleriKaşık MamasıBuharlı PişiriciTermal ÇantaSüt PompasıEmzirme ÖnlüğüEmzirme MinderiGöğüs PediGöğüs KremiTaşıma & GüvenlikBebek Arabası & PusetPark YatakAna KucağıPortbebe & KanguruYürüteçOto KoltuğuBaston PusetKanguruBebek SalıncaklarıBebek OdasıBebek BeşiğiBebek YatağıBebek NevresimleriOyuncak SepetleriBebek CibinlikOyuncak DolabıBebek Odası MobilyalarıBebek Oyun MatlarıBebek Oyun ParkıEv & MobilyaSofra & MutfakTencere & Tencere SetiTavaDüdüklü TencereYemek TakımıKahvaltı TakımıTabakÇatal Kaşık Bıçak SetiSaklama KabıBardakKahve FincanıEv GereçleriHurçDüzenleyicilerAskıÇamaşır SepetiBanyo DüzenleyiciBanyo SetleriÜtü Masası ve AksesuarlarıMakyaj & Takı OrganizeriEv TekstiliNevresim & Pike TakımıYastık & YorganÇarşaf & AlezYatak Örtüsü & BattaniyeUyku Seti Koltuk ÖrtüsüHavlu & BornozBanyo PaspasıHalı & KilimPerdeSeccadeEv DekorasyonAynaTabloDekoratif Çiçek & VazoKırlent & Kırlent KılıfıDuvar SaatiOda Kokusu & MumAydınlatmaAvizeLambaderMasa ve Gece LambasıMobilyaSalon & Oturma OdasıYatak OdasıBahçe MobilyasıÇalışma OdasıYemek OdasıOturma GruplarıGenç OdasıKoltuk TakımıMutfak DolabıŞifonyerMutfak TezgahıDolapGardıropSandalyeZigonHobiParti MalzemeleriMüzik Alet ve EkipmanlarıHediyelik ÜrünlerHobi MalzemeleriUzaktan Kumandalı AraçlarDroneOyun GruplarıHediye SepetiLed IşıkSpor & OutdoorKoşu BandıDumbell & AğırlıkPilates & YogaEliptik BisikletYoga MatıSporcu EldiveniPilates TopuSporcu SuluklarıTermoslarKitapSınav Hazırlık KitaplarıDers ve Yardımcı KitaplarRoman & Edebiyat KitaplarıKişisel Gelişim & Psikoloji KitaplarıÇocuk Bakım KitaplarıYabancı Dil Eğitim KitaplarıE-KitaplarDin KitaplarıÇizgi Roman ve MangaYabancı Dil Çocuk KitaplarıKırtasiyeDefterAjandaFotokopi KağıdıKalemBoya SetiDosyalama ArşivlemeMasaüstü GereçleriOfis TeknolojisiOtomobil & MotosikletOto AksesuarOto PaspasıOto LastikKaskKol Dayama & KolçakGüneşlik & PerdeAraç KokusuMotosiklet EldiveniMotosiklet BotuMotosiklet SepetiYapı MarketBanyo Yapı MalzemeleriElektrikli El AletiHırdavat ÜrünleriBoyaMatkapAmpulVidalamaSüpermarketEv & TemizlikÇamaşır YıkamaBulaşık YıkamaPaspas & MopÇamaşır DeterjanıBulaşık DeterjanıOda KokusuBanyo TemizleyicilerYumuşatıcıIslak MendilTuvalet KağıdıKağıt HavluTemizlik BeziKişisel BakımSaç BakımAğda & EpilasyonBanyo & DuşAğız BakımCilt BakımVücut BakımDeodorant ve Roll onŞarjlı Diş FırçalarıKadın HijyenKolonyaTıraş ÜrünleriGüneş ÜrünleriBebek BakımSüt Arttırıcı İçeceklerBebek Ek BesinBebek BeziIslak Mendil & HavluBebek KozmetikBebek Burun AspiratörüBebek Diş FırçasıBebek MamalarıBebek Diş MacunuBebek Temizleme PamuğuBebek Güneş KremiBebek PudrasıBebek Tırnak MakasıBebek YağıBebek Bakım SetiBebek ŞampuanıBebek KolonyasıBebek Bakım ÖrtüsüGıda ve İçecekÇayÖzel GıdaAtıştırmalıkKahvaltılıkKuru GıdaKahveMakarnaSalçaSıvı YağUnTuz & BaharatÇorbaGevrekYulafKonserveŞekerSütPasta SüslemeleriBitki ÇaylarıGazsız İçeceklerAtıştırmalıkKuru MeyveKuruyemişCipsÇikolataGofretBisküviKrakerŞekerlemeSakızProtein BarSağlıklı AtıştırmalıklarUnlu MamüllerKekPetshopKedi MamasıKedi KumuKöpek MamasıKedi VitaminiKöpek TasmasıKuş ÜrünleriAkvaryum ÜrünleriKedi Box & Taşıma ÇantalarıKedi ve Köpek OyuncaklarıKedi Yaş MamalarıKedi Ödül MamalarıKöpek Ödül MamalarıKısır Kedi MamalarıKedi ŞampuanıSu ve Mama KaplarıKuş YemleriKedi ve Köpek YataklarıYavru Kedi MamalarıAkvaryum Balık YemiKedi TuvaletiKedi Fırça ve TarağıKedi TırmalamasıKozmetikMakyajGöz MakyajıTen MakyajıDudak MakyajıMakyaj SetiOje & AsetonFondötenRujDudak KalemiMaskaraEyelinerGöz KalemiKapatıcılarAllıkHighlighterBB & CC KremKontür ve PaletlerPudraTakma TırnakFar PaletiCilt BakımıYüz KremiYüz TemizlemeYüz MaskesiGöz BakımıGüneş KoruyucuCilt SerumuEl & Ayak BakımıToniklerNemlendiricilerYüz MaskeleriPeelingEl KremleriVücut LosyonlarıSelülit KremleriMakyaj TemizleyiciGüneş KremleriAt Kılı FırçalarıCilt SıkılaştırıcılarVücut SpreyleriSaç BakımıŞampuanSaç ŞekillendiriciSaç Serumu & MaskesiSaç BoyasıMor ŞampuanKuru ŞampuanSaç KöpüğüSaç KremiFön SuyuSaç Bakım SpreyiRenk AçıcıGeçici Saç BoyalarıSaç MakasıTarakSaç BantlarıTokaSaç VitaminiSaç ToniğiWaxKişisel BakımDuş JelleriŞampuanPamukVücut SpreyleriParfümDeodorantAğız Bakım SuyuDiş FırçasıDiş MacunuDiş İpiŞarjlı Diş FırçalarıTörpülerKaş MakasıGünlük PedMesane PediKeseBanyo LifiDiş BeyazlatıcıGıda TakviyeleriParfüm & DeodorantParfümParfüm SetleriDeodorantVücut SpreyiSaç ŞekillendiriciSaç KöpüğüSaç SpreyiJöleWaxMakyaj AksesuarlarıMakyaj FırçalarıMakyaj SüngerleriMakyaj ÇantalarıCımbızKirpik KıvırıcıManikür & Pedikür SetleriEpilasyon & TıraşAğdaTıraş BıçağıEpilatörTıraş KöpüğüAğda BantlarıTüy Dökücü KremGenel BakımCinsel SağlıkHijyenik PedVücut BakımıEl ve Ayak BakımıDuş Jeli ve KremiBakım YağlarıAyak TörpüleriKatı SabunSıvı SabunPamukEl DezenfektanıAyakkabı & ÇantaKadın AyakkabıSpor AyakkabıTopuklu AyakkabıGünlük AyakkabıBot & BootieSandaletTerlikSneakerBabetLoaferAnne AyakkabısıTaşlı SandaletHastane TerlikleriTopuklu TerlikTopuklu BotÇizmeKovboy ÇizmesiDolgu Topuk AyakkabıKar BotuYağmur BotuPandufErkek AyakkabıSpor AyakkabıGünlük AyakkabıKlasik AyakkabıBotSneakerKoşu AyakkabısıKramponLoaferHalı Saha AyakkabısıSandaletBotÇizmePostalBasketbol AyakkabısıTerlikEv TerliğiPandufDeniz AyakkabısıSüet AyakkabıYürüyüş AyakkabısıÇocuk AyakkabıSpor AyakkabıGünlük AyakkabıBabetBotSneakerSandaletTerlikPandufÇizmeBasketbol AyakkabısıKramponÇocuk ÇantaSırt ÇantasıOkul ÇantasıÇekçekli ÇantaBeslenme ÇantasıLisanslı ÇantalarBel ÇantasıPostacı ÇantaErkek AksesuarSaatGüneş GözlüğüCüzdanKemerŞapkaBileklikKravatKolyeRozetPapyonKadın AksesuarSaatTakıŞapkaGüneş GözlüğüSaç AksesuarlarıKemerGümüş KolyeHasır BilezikKadın ÇantaOmuz ÇantasıSırt ÇantasıCüzdanSpor ÇantasıBel ÇantasıEl ÇantasıPortföyBez ÇantaKartlıkAbiye ÇantaPostacı ÇantasıPlaj ÇantasıLaptop ÇantasıKapitone ÇantaEvrak ÇantasıKutu ÇantaMakyaj ÇantasıPeluş ÇantaHasır ÇantaValiz & BavulErkek ÇantaSırt ÇantasıPostacı ÇantasıCüzdan & KartlıkSpor ÇantasıLaptop ÇantasıBel ÇantasıOmuz ÇantasıPortföy ÇantaTıraş ÇantasıOlta ÇantasıOkul ÇantasıValizOutdoor ÇantaEl ÇantasıElektronikKüçük Ev AletleriSüpürgeRobot SüpürgeDikey SüpürgeÜtüKahve MakinesiÇay MakinesiBlender SetiTost MakinesiDoğrayıcı & RondoSu Isıtıcı & KettleMikser & Mikser SetiAirfryer & FritözGiyilebilir TeknolojiAkıllı SaatAkıllı BileklikVR GözlükTelefonCep TelefonuAndroid Cep TelefonlarıiPhone Cep Telefonu Telefon KılıflarıŞarj CihazlarıPowerbankAraç İçi Telefon TutucuiPhone KılıflarKulaklıklarFoto & KameraAksiyon KameraFotoğraf MakinesiVideo KameraŞipşak Fotoğraf MakinesiDijital Fotoğraf MakinesiKamera LensleriHafıza KartıTV & Görüntü & SesTelevizyonSmart TVQLED TVOLED TVTV KumandalarıSoundbarProjeksiyon CihazıMedia PlayerHoparlörKulaklıkUydu AlıcısıÇanak AntenHDMI KabloAkım Korumalı PrizlerKablo & AdaptörLNBTV Ekran KoruyucuTV Askı AparatıKablolu HoparlörBeyaz EşyaBuzdolabıÇamaşır MakinesiBulaşık MakinesiKurutma MakinesiDerin DondurucuAnkastre SetlerKombiMikrodalga FırınAspiratörMini & Midi FırınAnkastre DavlumbazAnkastre OcakDijital Kod & ÜrünlerDijital Hediye KartlarıE-pin & Cüzdan KodlarıÖn Ödemeli KartlarBilgisayar & TabletBilgisayarlarTabletBilgisayar BileşenleriMonitörYazıcı & TarayıcıAğ & ModemKlavyeMouseGrafik TabletSSDRAMEkran KartıÇocuk Çizim TabletiKişisel Bakım AletleriSaç DüzleştiriciSaç MaşasıSaç Kurutma MakinesiTıraş MakinesiTartıEpilasyon AletleriIPL Lazer EpilasyonOyunculara ÖzelPlaystationXboxNintendoPlaystation OyunlarıKonsol AksesuarlarıOyuncu BilgisayarıOyuncu DonanımlarıOyuncu MonitörleriOyuncu KoltuğuOyuncu KulaklığıOyuncu MouseOyuncu KlavyesiBilgisayar OyunlarıElektronik AksesuarlarBilgisayar AksesuarTelefon AksesuarlarıTV AksesuarlarıVeri DepolamaKlima & IstıcılarKlimaKombiIsıtıcılarVantilatörŞofbenTermosifonHava TemizleyiciHava NemlendiriciSpor & OutdoorSpor Üst GiyimSpor TişörtCeket & YelekYağmurlukSpor SütyeniSweatshirtAtletFormaSpor MontSpor ŞapkaSpor Alt GiyimEşofman TakımıTaytŞortTermal GiyimÇorapSpor PantolonTerlikEşofmanSpor AyakkabıSneakerKoşu AyakkabısıHalı Saha AyakkabısıBasketbol AyakkabısıYürüyüş AyakkabısıOutdoor AyakkabıTenis AyakkabısıVoleybol AyakkabısıFitness AyakkabısıDeniz AyakkabısıOutdoor BotTerlikSandaletÇizmeBotKar BotuKayak AyakkabısıSnowboard BotuHavuz TerliğiEvde Spor AletleriElastik BantEl YayıMatÇalışma İstasyonlarıAtlama İpiBoks EldiveniDambıl SetiEliptik BisikletBarfiks BarıEldivenKettlebellKondisyon BisikletiYürüme BandıPilates TopuKürek Çekme AletiBoks BandajıCrossfitSpor MalzemeleriDeniz & PlajKaykayPatenKamp MalzemeleriDağcılık & TırmanışAksiyon KameraÇadır Uyku TulumuSu Sporu MalzemeleriDalış MalzemeleriBalıkçılık MalzemeleriTenis MalzemeleriKayak ve SnowboardOkçulukÇadırHavluSulukMatlarBisikletTermosPilates ToplarıBisikletÇocuk BisikletleriElektrikli BisikletlerBisikletçi EkipmanlarıBisiklet GözlükleriBisiklet KasklarıFitness KondisyonPilates MalzemeleriFitness AletleriKondisyon BisikletiKoşu BandıYoga MalzemeleriDambıl SetiAğırlık PlakalarıBarfiksSporcu BesinleriProtein TozuAmino AsitKarbonhidratL-Karnitin (CLA)Güç ve PerformansGıda Takviyesi & VitaminlerKreatinProtein BarShakerTopBasketbol TopuFutbol TopuKitap & Kırtasiye & HobiParti MalzemeleriLed IşıkDüğün & KınaYılbaşı SüsüYılbaşı AğacıBalonParti SetiHobi MalzemeleriÖrgü İpiBoncukKumaşNakış KitiÖrgü KitiMüzik AletleriPikap & GramofonGitar PlakPiyanoOrgKemanHediyelik ÜrünlerKonsept HediyelikFigürHediye KutusuKar KüresiPaketleme MalzemesiDroneUzaktan Kumandalı AraçlarOyun GruplarıPuzzleOyun KartlarıOkey TakımıSatrançMaketTavlaÇakmak ÜrünleriBenzinli ÇakmakKlasik ÇakmakKırtasiyeDefterAjandaEtiketSuluk & MataraYazı TahtasıPanoSilgiMakasYapıştırıcıOfisFotokopi KağıdıPil & Şarj CihazıYazarkasa ve TeraziHesap MakinesiDosya & KlasörZımba & DelgeçPara Sayma MakinesiCiltleme MakinesiOfis Sarf TüketimKalemKeçeli KalemFosforlu KalemUçlu KalemTükenmez KalemKurşun KalemKalem KutusuKalem UcuTahta KalemiTeknik Çizim KalemiBoya & Sanatsal MalzemelerAkrilik BoyaTuval & ŞövaleSanatsal KağıtKuru Boya KalemiFırçaKumaş BoyasıPastel BoyaSulu BoyaAhşap BoyasıEğitimSınav HazırlıkTYT & AYTKPSSLGSDers ve Yardımcı KitaplarTarihGüncel - Genel KonularSözlük & İmla KılavuzuTıp KitabıBilim & Teknik & MühendislikHukuk KitabıE-Kitap OkuyucuÇocuk ve Ebeveyn KitaplarıAktivite & Eğitici KitaplarÇocuk Masal ve Öykü KitabıÇocuk Bakımı & EbeveynlikBoyama KitaplarıSesli Çocuk KitaplarıDin ve MitolojiRoman ve EdebiyatRomanDünya EdebiyatıTürk EdebiyatıDeneme & İncelemeBiyografiŞiirAnı & Günlük & SeyahatnameKişisel GelişimBireysel GelişimYabancı Dil KitaplarYabancı Dil EğitimiYabancı Dil RomanYabancı Dil Çocuk KitaplarıHobi, Sanat, AkademikÇizgi Roman, Dergi ve Gazeteİş, Ekonomi & Pazarlama